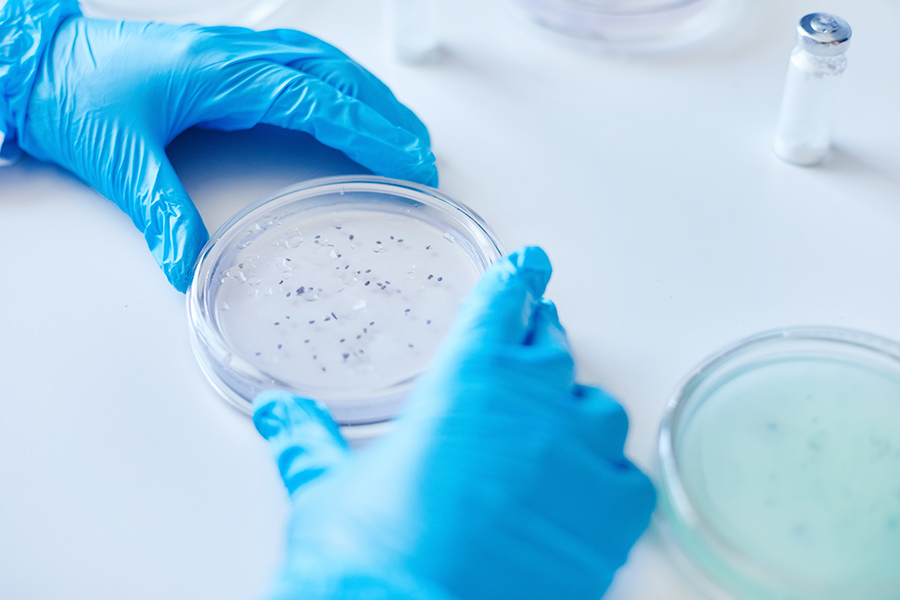
Top-down view of a person in bright blue medical gloves holding a clear petri dish containing small dark samples on a white lab table.

The Chilean Society of Microbiology (SOMICH) recently hosted its annual meeting, a premier event that convened over 400 researchers, students, and experts. The gathering showcased the latest advancements across diverse fields, including clinical, environmental, industrial, and agricultural microbiology.
Representing both the University of Santiago de Chile and the University of Chile, PDCM student Javiera Acevedo showcased her doctoral research at the conference. Her award-winning poster, “Protease Systems in Acidithiobacillus ferrooxidans: Differential Expression and Functional Characterization of Lon1 in Stress Response,” highlights a core component of her doctoral thesis.
“This recognition reflects not only my doctoral work but also the guidance I have received during my training,” said Javiera Acevedo. Her research explores the regulation and functional role of protease systems in A. ferrooxidans—a key microorganism in bioleaching and a primary model for studying life in extreme environments.
“The findings of this study contribute to understanding how acidophiles survive in extreme environments,” the researcher stated. She noted that the results are “relevant both to astrobiology and to the optimization of bioleaching processes, especially in the recovery of copper from sulfide minerals.” The study further suggests this survival is driven by the microorganism’s "adaptive role and specialized functions" tailored to specific environmental stressors.
Somich and PDCM
Regarding her experience at the conference, Javiera noted that it was “a pleasant experience. I was able to connect with scientists from similar fields and consider new approaches for future experiments.”
Beyond her research, Javiera emphasized the importance of the graduate program and the institutional support provided during her academic training.
“I am proud to represent the Usach–UChile Doctorate in Microbiology. The level of the research presented reflects the quality of the program,” said the graduate student, who conducted her experiments at the Usach Basic and Applied Microbiology Laboratory.
Finally, Javiera encouraged future researchers to participate in international scientific conferences: “Presenting your work opens doors, creates collaborations, and improves the way we communicate science,” noted the researcher, highlighting the impact of the EMBO PhD Course and the Doctorate program on her professional development.
The research presented at Somich 2025 was supported by Dicyt-Usach 022543LJ funding, supplemented by the USA 21991 mobility grant and ANID operational expenses.
Javiera, who joined the PhD program in 2023, is also currently participating in a Double Degree program with the University of Freiberg (TU Bergakademie Freiberg) in Germany.